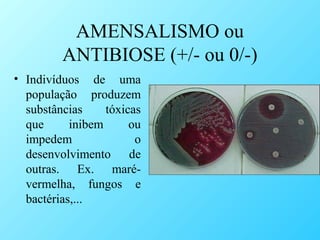
AMENSALISMO ou
ANTIBIOSE (+/- ou 0/-)
• Indivíduos de uma
população produzem
substâncias
tóxicas
que
inibem
ou
impedem
o
desenvolvimento de
outras. Ex. marévermelha, fungos e
bactérias,...

O documento discute as diferentes interações entre populações biológicas, incluindo relações harmônicas como mutualismo, comensalismo e inquilinismo, onde ambas as espécies se beneficiam ou uma se beneficia sem prejudicar a outra. Também aborda relações desarmônicas como competição, predador-presa, parasitismo e amensalismo, onde pelo menos uma espécie é prejudicada. Dá exemplos de cada tipo de interação como formigas e pulgões em mutualismo e onça e cutia em relação de predador-presa